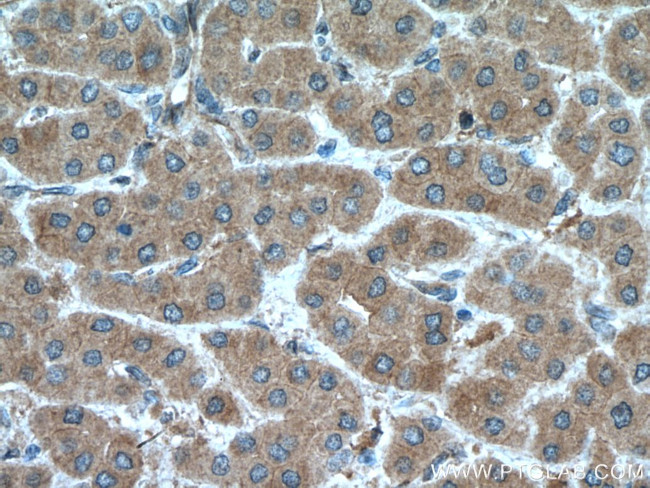
MGLL Antibody in Immunohistochemistry (Paraffin) (IHC (P))

Search
Proteintech
MGLL Polyclonal Antibody
{{$productOrderCtrl.translations['antibody.pdp.commerceCard.promotion.promotions']}}
{{$productOrderCtrl.translations['antibody.pdp.commerceCard.promotion.viewpromo']}}
{{$productOrderCtrl.translations['antibody.pdp.commerceCard.promotion.promocode']}}: {{promo.promoCode}} {{promo.promoTitle}} {{promo.promoDescription}}. {{$productOrderCtrl.translations['antibody.pdp.commerceCard.promotion.learnmore']}}
产品信息
14986-1-AP
种属反应
已发表种属
宿主/亚型
分类
类型
抗原
偶联物
形式
浓度
规格
纯化类型
保存液
内含物
保存条件
运输条件
产品详细信息
Immunogen sequence: METGPEDPS SMPEESSPRR TPQSIPYQDL PHLVNADGQY LFCRYWKPTG TPKALIFVSH GAGEHSGRYE ELARMLMGLD LLVFAHDHVG HGQSEGERMV VSDFHVFVRD VLQHVDSMQK DYPGLPVFLL GHSMGGAIAI LTAAERPGHF AGMVLISPLV LANPESATTF KVLAAKVLNL VLPNLSLGPI DSSVLSRNKT EVDIYNSDPL ICRAGLKVCF GIQLLNAVSR VERALPKLTV PFLLLQGSAD RLCDSKGAYL LMELAKSQDK TLKIYEGAYH VLHKELPEVT NSVFHEINMW VSQRTATAGT ASPP (1-313 aa encoded by BC000551)
靶标信息
Monoglyceride lipase functions together with hormone-sensitive lipase to hydrolyze intracellular triglyceride stores in adipocytes and other cells to fatty acids and glycerol. MGLL may also complement lipoprotein lipase in completing hydrolysis of monoglycerides resulting from degradation of lipoprotein triglycerides.
仅用于科研。不用于诊断过程。未经明确授权不得转售。
生物信息学
蛋白别名: HU-K5; Lysophospholipase homolog; Lysophospholipase-like; MAGL; MGL; MGLL; Monoacylglycerol lipase; Monoglyceride lipase; unnamed protein product
基因别名: AA589436; HU-K5; HUK5; MAGL; MGL; Mgl2; MGLL
UniProt ID: (Human) Q99685, (Rat) Q8R431, (Mouse) O35678
Entrez Gene ID: (Human) 11343, (Rat) 29254, (Mouse) 23945